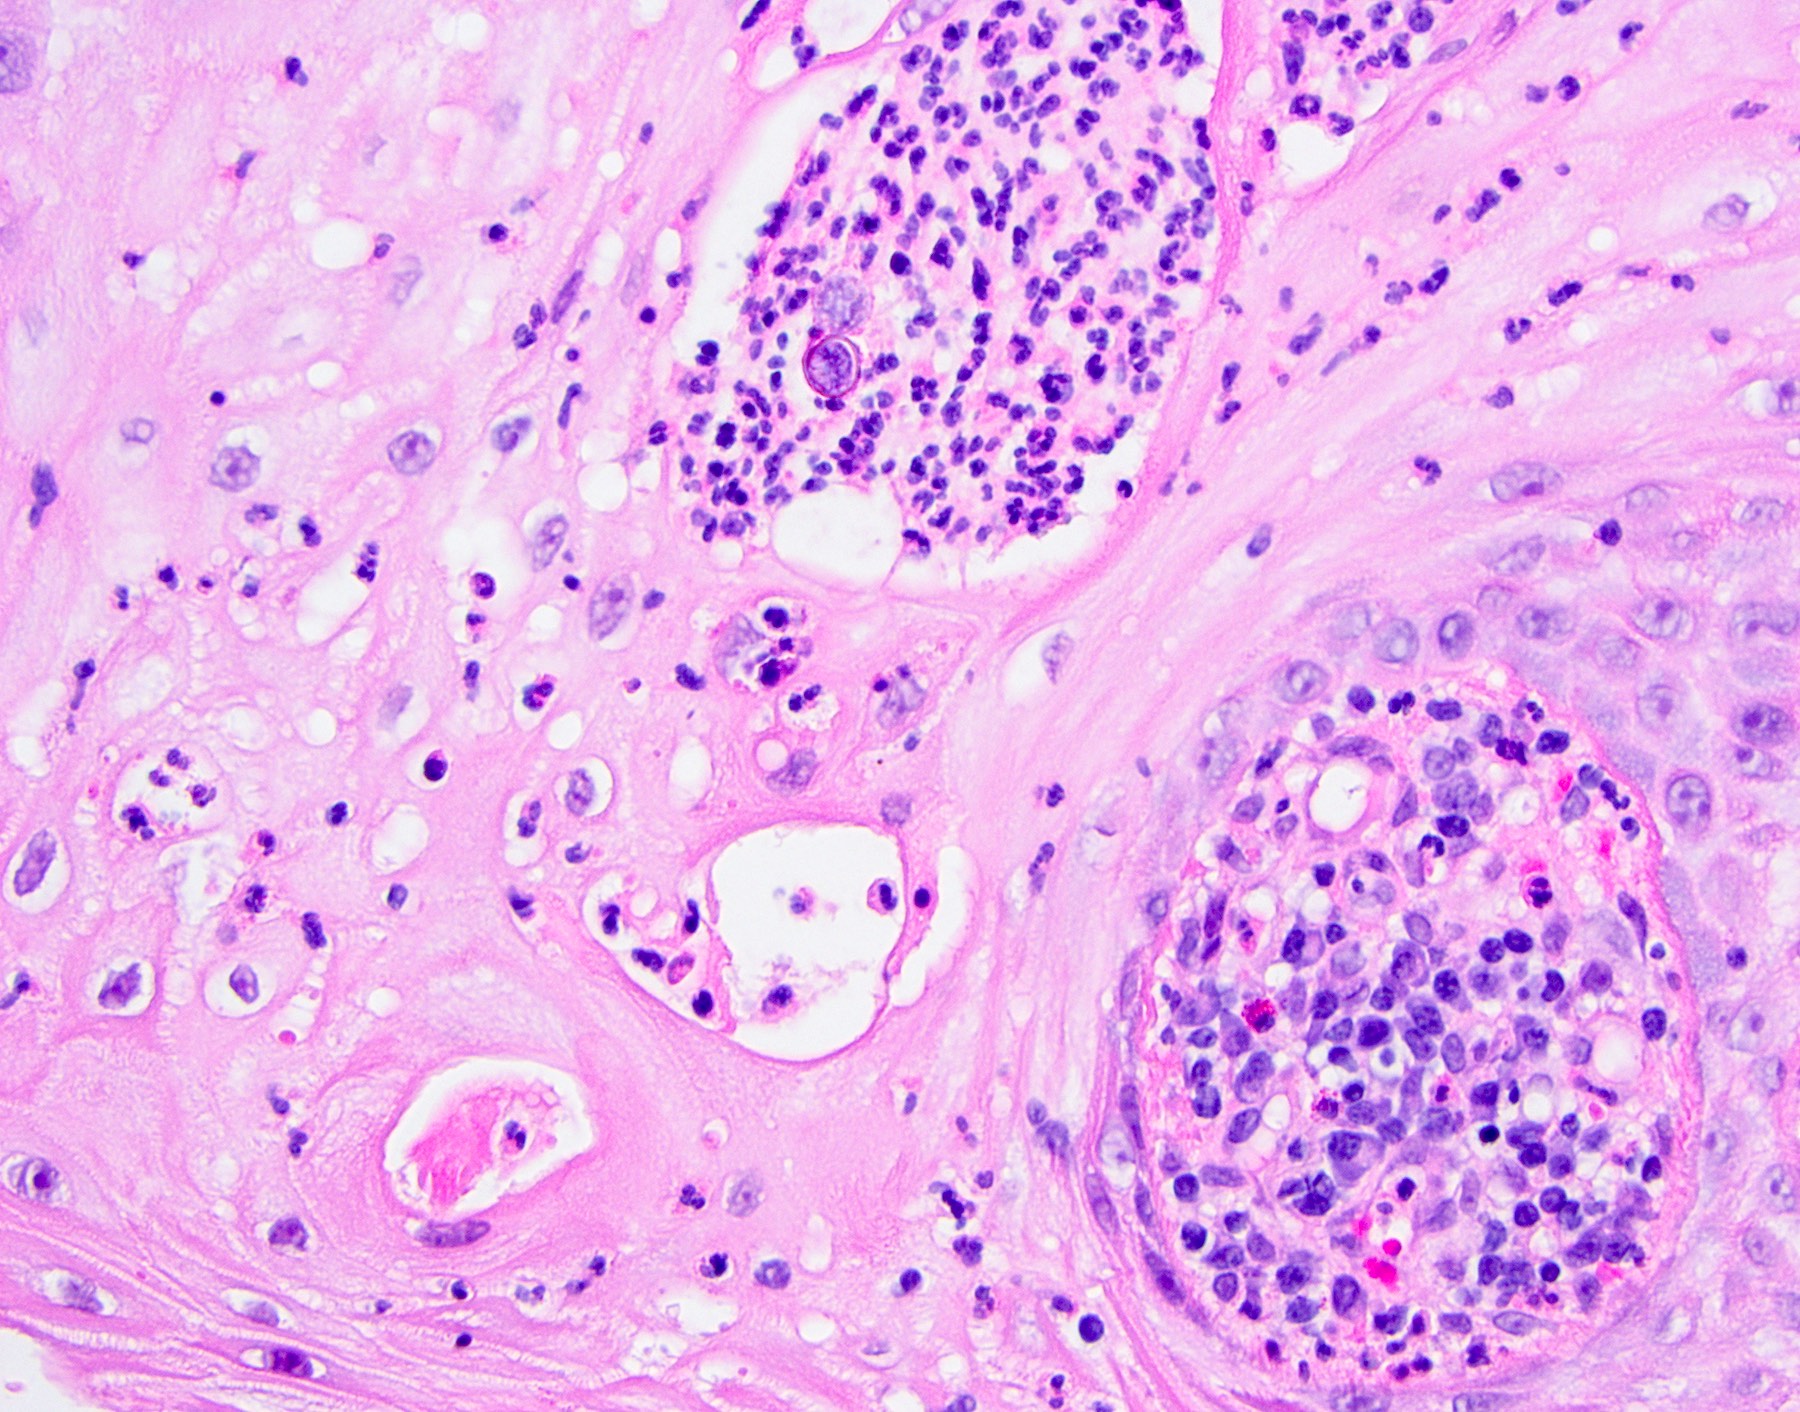

Table of Contents
Definition / general | Essential features | Terminology | Sites | Pathophysiology | Etiology | Clinical features | Diagnosis | Prognostic factors | Case reports | Treatment | Clinical images | Gross description | Microscopic (histologic) description | Microscopic (histologic) images | Virtual slides | Positive stains | Videos | Sample pathology report | Differential diagnosis | Practice question #1 | Practice answer #1 | Practice question #2 | Practice answer #2 | Practice question #3 | Practice answer #3Cite this page: Smith MH. Pseudoepitheliomatous hyperplasia. PathologyOutlines.com website. https://www.pathologyoutlines.com/topic/oralcavitypseudoephyperplasia.html. Accessed October 5th, 2025.
Definition / general
- Histopathological pattern characterized by the benign, reactive elongation of the epithelial rete ridges, which deceivingly may mimic squamous cell carcinoma
- Seen in a variety of conditions / tumors, namely granular cell tumor, candidiasis (median rhomboid glossitis, chronic hyperplastic candidiasis), necrotizing sialometaplasia, blastomycosis, granulomatosis with polyangiitis, etc. (Oral Dis 2020;26:573)
Essential features
- Microscopic pattern rather than a distinct diagnosis
- Benign hyperplasia of the epithelial rete ridges
- May be misdiagnosed as squamous cell carcinoma
- Seen in a wide variety of infectious, inflammatory, traumatic and neoplastic conditions (Am J Dermatopathol 2012;34:165)
Terminology
- Pathologists often use the acronym PEH
- Pseudocarcinomatous hyperplasia
Sites
- Not site specific; site predilection depends on the primary diagnosis
- Oral granular cell tumors most commonly occur on the dorsal tongue, necrotizing sialometaplasia is most commonly on the hard palate and median rhomboid glossitis occurs on the posterior dorsal tongue at the midline (Oral Dis 2020;26:573)
Pathophysiology
- Unknown
- Possible role of transforming growth factor alpha (TGF alpha) in PEH development via autocrine growth effect or by blocking downregulation of epidermal growth factor receptor (EGFR) (Ann Diagn Pathol 2003;7:73, Am J Dermatopathol 2012;34:165)
Etiology
- Reported in a variety of conditions / tumors
- Granular cell tumor (Oral Dis 2020;26:573)
- Candidiasis (median rhomboid glossitis, chronic hyperplastic candidiasis) (J Int Oral Health 2015;7:148)
- Reactive proliferations, such as epulis fissuratum (J Int Oral Health 2015;7:148)
- Necrotizing sialometaplasia (Oral Surg Oral Med Oral Pathol Oral Radiol Endod 2000;89:600)
- Deep chronic infections, such as blastomycosis (Am J Dermatopathol 2011;33:112)
- Granulomatosis with polyangiitis (Intractable Rare Dis Res 2022;11:93)
- Oral submucous fibrosis (Oral Surg Oral Med Oral Pathol Oral Radiol Endod 2008;106:556)
- Melanocytic nevi (Int J Oral Maxillofac Surg 2002;31:330)
- Melanoma (J Cutan Pathol 2000;27:153)
Clinical features
- Clinical appearance dictated by the condition / background setting in which PEH is found
- For example, PEH in chronic hyperplastic candidiasis may manifest as a well demarcated plaque
- Granular cell tumors present as dome shaped, often yellow nodules (Am J Dermatopathol 2011;33:112)
Diagnosis
- Biopsy with clinicopathologic correlation, sometimes with review of multiple levels (Am J Dermatopathol 2011;33:112)
- Diagnosis of PEH is made with significant caution, as atypical epithelial processes (e.g., verrucous carcinoma, proliferative verrucous leukoplakia, squamous cell carcinoma) may imitate PEH
- Misdiagnosis of PEH as squamous cell carcinoma may lead to radical surgery or surgery related morbidity (J Cutan Aesthet Surg 2014;7:232)
- Double reporting or obtaining a second opinion aids in preventing misdiagnosis of PEH for squamous cell carcinoma and vice versa (Eur Arch Otorhinolaryngol 2014;271:847)
- Special stains may be necessary to diagnose infections
Prognostic factors
- Prognosis dictated by primary diagnosis
Case reports
- 27 year old woman with PEH in necrotizing sialometaplasia (Dermatol Online J 2020;26:13030)
- 32 year old man with granulomatosis with polyangiitis of the gingiva showing PEH on biopsy (Intractable Rare Dis Res 2022;11:93)
- 44 year old white man with granular cell tumor showing PEH (BMC Res Notes 2017;10:14)
- 62 year old man with PEH in an intramucosal nevus (Int J Oral Maxillofac Surg 2002;31:330)
Treatment
- Depends on primary diagnosis
Clinical images
Gross description
- Depends on the underlying diagnosis (e.g., granular cell tumor, blastomycosis, etc.) but in general, thickening of the epithelium is noted
- Tan, although may be pigmented if overlying a nevus or melanoma (Am J Dermatopathol 2011;33:112)
Microscopic (histologic) description
- Thick elongation of the overlying epithelium with bulbous or sometimes jagged / sharp, interconnecting rete ridges (Am J Dermatopathol 2011;33:112)
- May exhibit keratin pearl formation: concentric layers of keratinocytes with central keratinization (Am J Dermatopathol 2011;33:112)
- Lacks significant nuclear atypia; although mitotic figures may be seen, they are not numerous or atypical (Am J Dermatopathol 2011;33:112)
- Awareness of microscopic features seen in conditions / tumors associated with PEH is paramount for proper diagnosis
- Prominent leukocytic exocytosis or extravasated red blood cells should alert the pathologist to look for infection (candidiasis, blastomycosis, etc.) or granulomatosis with polyangiitis (Am J Dermatopathol 2011;33:112)
- Replacement of underlying fibrous stroma with sheets of pale, basophilic, plump granular cells suggests that the overlying epithelial proliferation is likely associated with granular cell tumor
- Connection with metaplastic salivary ducts and presence of spilled mucin suggests necrotizing sialometaplasia
- Underlying stromal fibrosis may be seen in oral submucous fibrosis (in a patient who uses betel quid) or in median rhomboid glossitis, as the posterior dorsal tongue is a region that tends to exhibit prominent fibrosis of the stroma
Microscopic (histologic) images
Positive stains
- Usually not utilized for diagnosis as clinicopathologic correlation is often the most valuable
- Special stains PAS or GMS may highlight the underlying infectious process
- p53 reportedly positive only in basilar portion of epithelium (differentiated keratinocytes not stained) (Am J Dermatopathol 2011;33:112, Arch Pathol Lab Med 2005;129:1032, Cancer 1994;73:2317)
Videos
PEH in excision of skin lesion
Definition, causes and histologic appearance of PEH
PEH in granular cell tumor
Sample pathology report
- Dorsal tongue, incisional biopsy:
- Hyperparakeratosis, epithelial hyperplasia and superficial candidal colonization (see comment)
- Comment: The microscopic pattern of epithelial hyperplasia is suggestive of pseudoepitheliomatous hyperplasia, likely caused by the presence of candidiasis. If lesional tissue persists after adequate antifungal therapy, however, rebiopsy is recommended in order to rule out atypical epithelial processes that may mimic pseudoepitheliomatous hyperplasia.
Differential diagnosis
- Squamous cell carcinoma (SCC):
- May be difficult to differentiate from PEH on small biopsies or without supplemental clinical information
- Demonstrates significant cellular atypia and increased / abnormal mitotic figures
- Frankly invasive islands that lack surrounding basement membrane
- May show perineural, lymphovascular, skeletal muscle or ductal invasion
- p53 reportedly positive throughout full thickness in SCCs as opposed to in PEH, where it highlights only the basilar portion (Arch Pathol Lab Med 2005;129:1032, Am J Dermatopathol 2011;33:112)
- In cases with secondary candidiasis, repeat biopsy after antifungal therapy may aid in determining a more definitive diagnosis
- Verrucous carcinoma:
- May be difficult to differentiate from PEH on small biopsies or without supplemental clinical information
- Church spire-like or papillary hyperkeratosis with deep keratin clefting
- Broad, bulbous, plunging rete ridges that demonstrate pushing encroachment on muscle or other deep submucosal structures, below the level of intact normal epithelium (Head Neck Pathol 2021;15:572)
- Persists despite antifungal therapy
- In cases with secondary candidiasis, repeat biopsy after antifungal therapy may aid in determining a more definitive diagnosis
- Bulky hyperkeratotic epithelial proliferation in proliferative verrucous leukoplakia (PVL) (Head Neck Pathol 2021;15:572):
- May be difficult to differentiate from PEH on small biopsies or without supplemental clinical information
- Generalized thickened epithelium
- Bulbous rete pegs that sometimes coalesce
- Lichenoid inflammation may be present
- High risk of progression into malignancy if untreated
- Associated with multifocal lesions
- Persists despite antifungal therapy
- High risk sites in order: gingiva > soft palate > floor of mouth > buccal > tongue
Practice question #1
Practice answer #1
A. Pseudoepitheliomatous hyperplasia. When combined with the clinical information / photograph, the overall diagnosis of this case is median rhomboid glossitis, which is a particular diagnosis made in a patient with a red patch on the middle portion of the posterior dorsal tongue. The epithelium often shows elongated, bulbous shaped rete ridges (pseudoepitheliomatous hyperplasia) and superficial candidal colonization, as highlighted here by a PAS stain. Answer B is incorrect because the epithelium does not show significant atypia or detached islands of invasive epithelium. Answer C is incorrect because there are no salivary ducts pictured above; however, squamous ductal metaplasia may be seen in association with pseudoepitheliomatous hyperplasia in a setting of necrotizing sialometaplasia, a condition most often diagnosed on the hard palate. Answer D is incorrect because although the epithelium is bulbous and hyperplasic, a prominent verrucoid surface architecture and keratin clefting are not identified.
Comment Here
Reference: Pseudoepitheliomatous hyperplasia
Comment Here
Reference: Pseudoepitheliomatous hyperplasia
Practice question #2
Practice answer #2
B. Granular cell tumor with overlying pseudoepitheliomatous hyperplasia (PEH). Microscopic sections show a dome shaped mass of pale, basophilic, plump granular cells surfaced by hyperkeratotic and hyperplastic epithelium. Although the rete ridges are significantly proliferative and demonstrate keratin pearls, overt cytologic atypia is not appreciated. This proliferative pattern of the epithelium is termed pseudoepitheliomatous hyperplasia and is known to be associated with granular cell tumors. Answer A is incorrect because although there is a thickened layer of parakeratin, this answer choice ignores the replacement of the fibrous stroma by plump granular cells. Answer C, a common pitfall in the diagnosis of this tumor, is incorrect because although the epithelium is proliferative, prominent cytologic atypia is not appreciated. The pathologist must be keen in recognizing the underlying replacement of the fibrous stroma with plump granular cells and must know that granular cell tumors characteristically show PEH in many cases. Answer D is incorrect because verrucous carcinoma would show keratin clefting and prominent, bulbous, plunging rete ridges that push into the underlying muscle.
Comment Here
Reference: Pseudoepitheliomatous hyperplasia
Comment Here
Reference: Pseudoepitheliomatous hyperplasia
Practice question #3
Practice answer #3
A. Blastomycosis with pseudoepitheliomatous hyperplasia. Blastomycosis is one of the conditions that characteristically shows pseudoepitheliomatous hyperplasia (PEH) in which the epithelium is thickened and forms elongated and anastomosing rete ridges. Answer D is incorrect because although blastomycosis has often been misdiagnosed as squamous cell carcinoma (SCC) due to this prominent PEH, neutrophilic abscesses throughout the epithelium should prompt the pathologist into getting infectious stains, such as the GMS shown above. The GMS stain highlights the thick walled blastomycosis organisms, which show broad based budding. SCC is a common pitfall in the diagnosis of blastomycosis but is incorrect because fungal stains are negative for deep organisms in SCC. Answer B is incorrect because granulomatosis with polyangiitis (GPA) also demonstrates dense inflammation and PEH; however, GPA has evidence of vasculitis and a lack of deep fungal organisms. Answer C is incorrect because pyogenic granulomas can also show dense inflammation and some degree of PEH; however, the epithelium is often not this prolific and microorganisms would not be present on GMS staining.
Comment Here
Reference: Pseudoepitheliomatous hyperplasia
Comment Here
Reference: Pseudoepitheliomatous hyperplasia